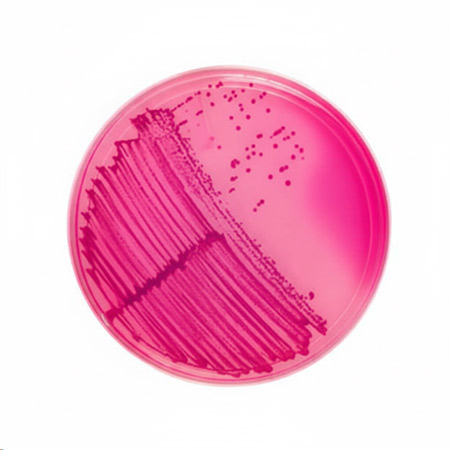
تفاوت محیط کشت انتخابی و افتراقی
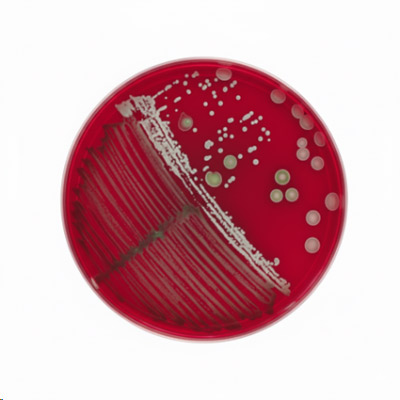
تفاوت محیط کشت انتخابی و افتراقی
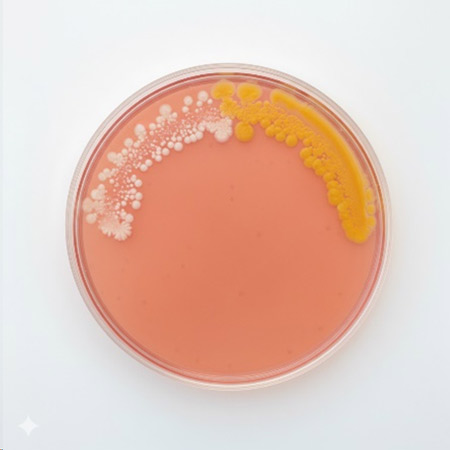
تفاوت محیط کشت انتخابی و افتراقی

تفاوت محیط کشت انتخابی و افتراقی

در میکروبیولوژی، انتخاب درست محیط کشت تقریبا به اندازه انتخاب تست درست اهمیت دارد. محیط های انتخابی برای رشد دادن یک گروه هدف و مهار بقیه طراحی میشوند، در حالی که محیطهای افتراقی برای تشخیص و متمایز کردن میکروارگانیسمها روی یک محیط مشترک به کار میروند.
در این مقاله توضیح میدهیم محیط کشت انتخابی دقیقا چه کاری انجام میدهد، محیط کشت افتراقی چه اطلاعاتی به شما اضافه میکند و در عمل چطور بین این دو انتخاب کنید. هدف این است که بعد از مطالعه، هنگام سفارش و استفاده از محیط کشت آماده از فروشگاه نیکو، تصمیم شما آگاهانه و قابل دفاع باشد؛ چه در آزمایشگاه تشخیصی کار کنید، چه در کنترل کیفیت صنایع غذایی، دارویی یا بهداشتی.
محیط کشت انتخابی چیست؟
محیط کشت انتخابی اجازه رشد یک گروه خاص از میکروارگانیسمها را میدهد و رشد بقیه را متوقف یا به شدت محدود میکند. این انتخابگری معمولا با افزودن موادی مانند آنتیبیوتیکها، املاح صفراوی، رنگهای مهارکننده یا غلظت بالای نمک ایجاد میشود
بطور خلاصه محیط کشت انتخابی برای رشد «میکرو ارگانیسمهای هدف» طراحی شده است و با افزودن عامل مهارکننده، رشد میکروب های ناخواسته را قطع یا کم میکنند. برای درک بهتر مفهوم محیط کشت انتخابی، بد نیست چند نمونه شناخته شده از این نوع محیطها را مرور کنیم:
محیط کشت مانیتول سالت آگار
مانیتول سالت آگار یک نمونهی کلاسیک از محیط کشت انتخابی است. وجود حدود ۷٫۵٪ NaCl در این محیط، باعث میشود بسیاری از باکتریها نتوانند رشد کنند؛ اما استافیلوکوکوس ها (Staphylococcus) به دلیل سازگاری با محیطهای پرنمک (مثل پوست انسان) بهخوبی رشد میکنند. در نتیجه، اگر روی این محیط کشت نمک بزنید، در واقع به رشد استافیلوکوکوس ها کمک کرده اید.
محیط کشت مک کانگی آگار
مک کانگی آگار هم یکی از معروفترین محیطهای انتخابی است. در ترکیب این محیط، املاح صفراوی و کریستال ویوله وجود دارد که از رشد باکتریهای گرم مثبت جلوگیری میکنند. در نتیجه بیشتر باسیلهای گرم منفی رودهای روی این محیط رشد میکنند. قابل ذکر است این محیط کشت هم افتراقی است و هم انتخابی.
محیط کشت افتراقی چیست؟
محیط کشت افتراقی (Differential media) نوعی محیط کشت میکروبی است که طوری طراحی شده تا چند نوع میکروارگانیسم مختلف بتوانند روی آن رشد کنند، اما به کمک مواد خاص و اندیکاتورهای رنگی باعث میشود ظاهر کلنیها یا محیط بین این میکروبها فرق کند.
در ادامه، چند محیط کشت افتراقی مهم را معرفی میکنیم که در تشخیص و افتراق باکتریها نقش کلیدی دارند:
محیط کشت بلاد آگار
بلاد آگار یک محیط غنی شده و در عین حال افتراقی است. تقریباً بسیاری از باکتریهای مقاوم روی این محیط رشد میکنند، اما تفاوت در نوع همولیز باعث میشود کلنیها الگوی متفاوتی ایجاد کنند. در همولیز کامل (β) دور کلنی یک ناحیه شفاف دیده میشود، در همولیز ناقص (α) هالهای سبز رنگ ایجاد میشود و در حالت بدون همولیز (γ) تغییری در اطراف کلنی دیده نمیشود. همین الگوی همولیز، مخصوصاً برای تشخیص استرپتوکوکوس ها اهمیت ویژه دارد.
محیط کشت TSI آگار
محیط کشت TSI یک محیط آگار نیمه جامد و افتراقی است که برای شناسایی باسیلهای گرممنفی رودهای استفاده میشود. این محیط سه قند (گلوکز، لاکتوز، ساکارز)، اندیکاتور pH و ترکیبات حاوی آهن دارد و بر اساس تغییر رنگ، تولید گاز و تشکیل رسوب سیاه H₂S تفسیر میشود. با نگاه کردن به شیب و ته لوله TSI، میتوان الگوی تخمیر قند و تولید H₂S را دید و گونه های مختلف انتروباکتریاسه (مثل سالمونلا، شیگلا، اشرشیا کلی و…) را از هم جدا کرد.
محیط کشت سولفید ایندول
محیط کشت SIM یک محیط افتراقی نیمهجامد است و مانند TSI معمولا برای گونههای مختلف Enterobacteriaceae استفاده میشود. این محیط سه تست را همزمان در خودش انجام میدهد: تولید H₂S، تولید ایندول و بررسی تحرک باکتری. تغییر رنگ محیط، رسوب سیاه و نحوه پخش شدن رشد در لوله SIM، یک تصویر واضح از رفتار میکروب به شما میدهد و کمک میکند باسیلهای رودهای مختلف را از هم تشخیص بدهید.
محیطهایی انتخابی-افتراقی
محیطهای کشت انتخابی-افتراقی محیطهایی هستند که دو کار را هم زمان انجام میدهند؛ ابتدا، با استفاده از مواد مهارکننده (مثل نمک بالا، املاح صفراوی یا رنگ ها) فقط اجازه رشد یک گروه خاص از باکتریها را میدهند و بقیه را محدود میکنند ( دوم، با کمک قندها و اندیکاتورهای pH یا مواد واکنش گر دیگر، باعث تغییر رنگ یا ظاهر کلنی ها میشوند تا بتوانیم بین همین باکتری های انتخاب شده هم تفاوت قائل شویم
محیطهایی مثل مک کانگی آگار و مانیتول سالت (MSA) از این قبیل موارد هستند.
محیط کشت مانیتول سالت آگار
محیط کشت مانیتول سالت آگار (MSA) یک محیط همزمان انتخابی و افتراقی است. بهخاطر غلظت بالای نمک (حدود ۷٫۵٪)، بیشتر باکتریها روی آن رشد نمیکنند و در عمل عمدتاً استافیلوکوکوس ها باقی میمانند؛ به همین دلیل برای آنها محیطی انتخابی بهحساب میآید. از طرف دیگر، وجود قند مانیتول و اندیکاتور pH فنول رد باعث میشود بین استافیلوکوکوس هایی که مانیتول را تخمیر میکنند و محیط را زرد میکنند (مثل S. aureus و گونههایی که مانیتول را تخمیر نمیکنند و رنگ محیط را تغییر نمیدهند، افتراق ایجاد شود.
محیط کشت مک کانگی آگار
محیط کشت مک کانکی آگار (MacConkey Agar) هم یک محیط انتخابی–افتراقی کلاسیک است. در این محیط، املاح صفراوی و کریستال ویوله رشد بیشتر باکتریهای گرم مثبت را مهار میکنند و آن را برای باسیلهای گرم منفی رودهای انتخابی میسازند. همزمان، وجود لاکتوز و اندیکاتور pH Neutral Red باعث میشود باکتریهای لاکتوز مثبت کلنیهای صورتی/قرمز تشکیل دهند و لاکتوز منفیها بیرنگ باقی بمانند؛ به این ترتیب MacConkey هم انتخابی است و هم افتراقی.
انتخاب محیط کشت بر اساس نوع نمونه و هدف تست
وقتی میخواهید بین محیط کشت انتخابی و محیط کشت افتراقی یکی را انتخاب کنید، اول باید به دو سؤال ساده جواب بدهید:
اول اینکه نمونه شما از چه نوعی است؛ بالینی، غذایی، نمونه محیطی است یا آب و فاضلاب؟
دوم اینکه هدف شما فقط جداسازی یک گروه خاص از میکروارگانیسمهاست یا میخواهید در مرحله بعد، بین گونههای مختلف هم افتراق بدهید.
برای نمونههای خیلی آلوده و مخلوط مثل مدفوع، مواد غذایی و سوابهای محیطی، معمولاً کار را با محیطهای انتخابی یا انتخابی–افتراقی شروع میکنند؛برای این امر محیطهایی مثل محیط کشت مک کانگی آگار که فقط روی گروههای هدف متمرکز اند بسیار مناسب اند. بعد از این مرحله و وقتی گروه هدف جدا شد، برای تشخیص دقیقتر، از محیطهای افتراقی مثل بلاد آگار، TSI و سولفید ایندول استفاده میشود تا بر اساس الگوهای همولیز، تخمیر قندها، تولید گاز، تشکیل H₂S و سایر واکنشهای بیوشیمیایی بین باکتریها تفاوت قائل شویم.
لازم به ذکر است که در کنار تمام این محیطها، داشتن یک محیط عمومی مثل Nutrient Agar هم ضروری است؛ چون برای رشد اولیه، نگهداری سویهها و انجام بسیاری از تستهای تکمیلی به آن نیاز دارید.
محیط کشت آماده مصرف یا محیط کشت پودری؟
محیط کشت آماده مصرف برای آزمایشگاههایی مناسب است که میخواهند زمان و نیروی خود را صرف انجام آزمونها کنند نه آمادهسازی محیط. این محیطها در کارخانه، با فرمول استاندارد، استریل و کنترل کیفی میشوند و بهصورت پلیت یا لوله آماده تحویل داده میشوند؛ بنابراین ریسک آلودگی و خطای انسانی و به حداقل میرسد. در آزمایشگاههای تحت استاندارد و مراکز با حجم نمونه بالا، استفاده از محیط آماده مصرف معمولاً از نظر کیفیت و رگولاتوری انتخاب مطمئنتری است.
در مقابل، محیط کشت پودری برای آزمایشگاههایی مناسب است که تجهیزات کامل، نیروی آموزشدیده و حجم مصرف بالای محیط دارند. در این حالت، محیط بهصورت پودر غلیظ تحویل گرفته میشود و آمادهسازی، استریلسازی و کنترل کیفیت آن بر عهدهی خود آزمایشگاه است؛ در نتیجه هزینهی تمامشده برای هر پلیت در بلندمدت کمتر میشود و امکان تنظیم حجم و ترکیب متناسب با نیاز وجود دارد. با این حال، باید توجه داشت که استفاده از محیط پودری مستلزم صرف زمان، رعایت دقیق دستورالعملها و پذیرش مسئولیت کامل کیفیت محیط آمادهشده است.
برای خرید انواع محیط کشت آماده به فروشگاه نیکو مراجعه کنید
در یک نگاه کلی، محیط کشت انتخابی (Selective media) برای این طراحی شده که رشد یک گروه خاص از میکروارگانیسمها را ممکن کند و بقیه را مهار کند؛ یعنی با افزودن عوامل مهارکننده، فقط ارگانیسمهای هدف باقی میمانند. در مقابل، محیط کشت افتراقی (Differential media) بهجای مهار رشد، از ویژگیهای بیوشیمیایی و اندیکاتورهای رنگی استفاده میکند تا تفاوتهای متابولیکی میکروارگانیسمها را روی یک محیط مشترک قابل مشاهده کند.
در عمل، آزمایشگاههای حرفهای از ترکیبی از محیطهای انتخابی، افتراقی و انتخابی–افتراقی استفاده میکنند تا هم جداسازی اولیه نمونه های پیچیده را انجام دهند و هم به تشخیص نهایی برسند. فروشگاه نیکو با ارائهی طیف کامل محیط های کشت آماده و پودری برای باکتری های گرم مثبت و منفی، به شما کمک میکند براساس نوع نمونه و نوع تست، بهترین انتخاب را داشته باشید.
سوالات متداول
۱. محیط کشت انتخابی چه زمانی استفاده میشود؟
وقتی نمونهی شما حاوی مخلوطی از میکروارگانیسمها است و میخواهید ابتدا فقط یک گروه خاص مانند باسیل های گرم منفی رودهای یا استافیلوکوک ها را جدا کنید، استفاده از محیط کشت انتخابی بهترین گزینه است. این محیطها به کمک نمک بالا، املاح صفراوی یا سایر عوامل مهارکننده، رشد میکروب های غیر هدف را کاهش میدهند و تمرکز شما را روی ارگانیسم های هدف قرار میدهند.
۲. آیا محیط کشت افتراقی میکروارگانیسمها را میکشد؟
خیر. طبق منابع آموزشی، محیط کشت افتراقی برای کشتن نیست، برای متمایز کردن است. این محیط ها اجازه رشد به گروه های مختلف میکروارگانیسمها را میدهند، اما با کمک اندیکاتورها و واکنش های بیوشیمیایی، تفاوت بین آنها را به صورت تغییر رنگ یا ظاهر نشان میدهند.
۳. آیا یک محیط میتواند هم انتخابی باشد هم افتراقی؟
بله، و اتفاقا بسیاری از محیط های پرکاربرد مثل مک کانکی و (MSA) دقیقاً همین طور هستند. این محیطها با استفاده از عوامل مهارکننده، رشد یک گروه خاص را انتخاب میکنند و در عین حال با استفاده از قندها و اندیکاتورها، تفاوت متابولیکی بین گونه ها را هم نشان میدهند.
محصولات مشابه:
پلیت یکبار مصرف ۸ سانت